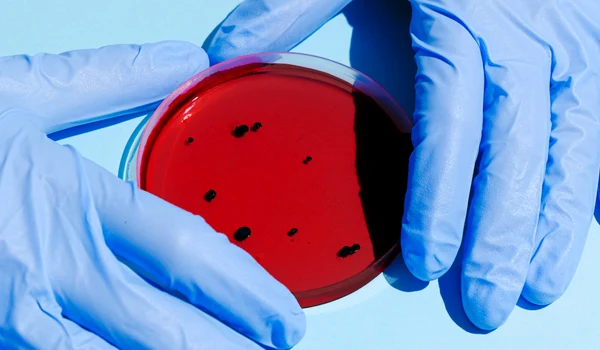
image

Un bistriţean printre naufragiaţii din Italia
0Un tânăr bistriţean de 27 de ani din Bistriţa se afla şi el printre angajaţii de pe vasul de croazieră italian care a naufragiat vineri pe coasta Concordiei.
Dan C, un tânăr bistriţean de 27 de ani lucra din vară pe vasul de croazieră italian şi se afla la bord în momentul în care a avut loc naufragiul. Din fericire, Dan a reuşit să se salveze şi să ajungă în siguranţă pe uscat.
Tânărul a sunat-o pe sora lui aflată în Bistriţa şi i-a spus că este în siguranţă în Livorno. Tânărul avea telefonul la el pe tot parcursul operaţiunii de salvare şi a putut să ţină legătura cu sora sa.
Deşi Dan trebuia să se întoarcă acasă abia în vara acestui an, se pare că va ajunge în Bistriţa mai repede decât se aşteptanu se cunoaşte însă cu exactitate data la care va ajunge în România şi nici care sunt procedurile care trebuie realizate pentru a putea pleca de acolo, mai ales că toţi naufragiaţii au rămas fără bagaje, haine şi alte bunuri personale pe care le aveau pe vas.
UPDATE
Sora lui din Bistriţa spune că ultima dată când a vorbit cu Dan acesta era cazat la un hotel din oraşul Grosseto. „M-a sunat prima dată chiar vineri noaptea când încă era pe vas şi aşteptau să vină bărcile pazei de coastă să le ofere ajutor şi să-i transporte de pe vas pe uscat. Acum este bine şi în siguranţă la un hotel din Grosseto şi aşteptăm să primim informaţii despre procedurile care trebuie urmate pentru a se întoarce în ţară", explică Anamaria, sora lui Dan.
Tânărul din Bistriţa era prima dată pe un vas de croazieră şi a ajuns acolo în vară cu un contract de muncă, lucrând ca şi vânzător într-un magazin. Anamaria spune că relaţia pe care a avut cu autorităţile române atât de la Ministerul de Externe cât şi ambasada şi consulatul din Italia a fost una foarte bună. „Am fost chiar şi noi surprinşi de interesul pe care l-au manifestat autorităţile faţă de noi şi de fratele meu. Sâmbătă dimineaţa am sunat eu şi am anunţat că fratele meu a fost pe vas şi de atunci am fost sunată de mai multe ori în legătură cu acest caz", spune bistriţeanca.